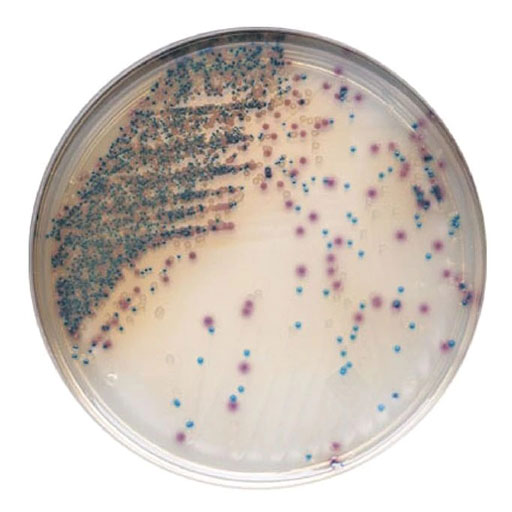

محیط کشت یست مولد آگار ایبرسکو گرید آزمایشگاهی
نام انگلیسی: Yeast Mold Agar (YMA) YM Agar
شناسه محصول:
bu1061
دسته: کالای زیستی, محیط کشت, محیط کشت یست مولد آگار Yeast Mold Agar (YMA)
برچسب: Yeast Mold Agar (YMA), محیط کشت یست مولد آگار
197,000 تومان – 689,000 تومانمحدوده قیمت: 197,000 تومان تا 689,000 تومان
12
نفر در حال مشاهده این محصول هستند!